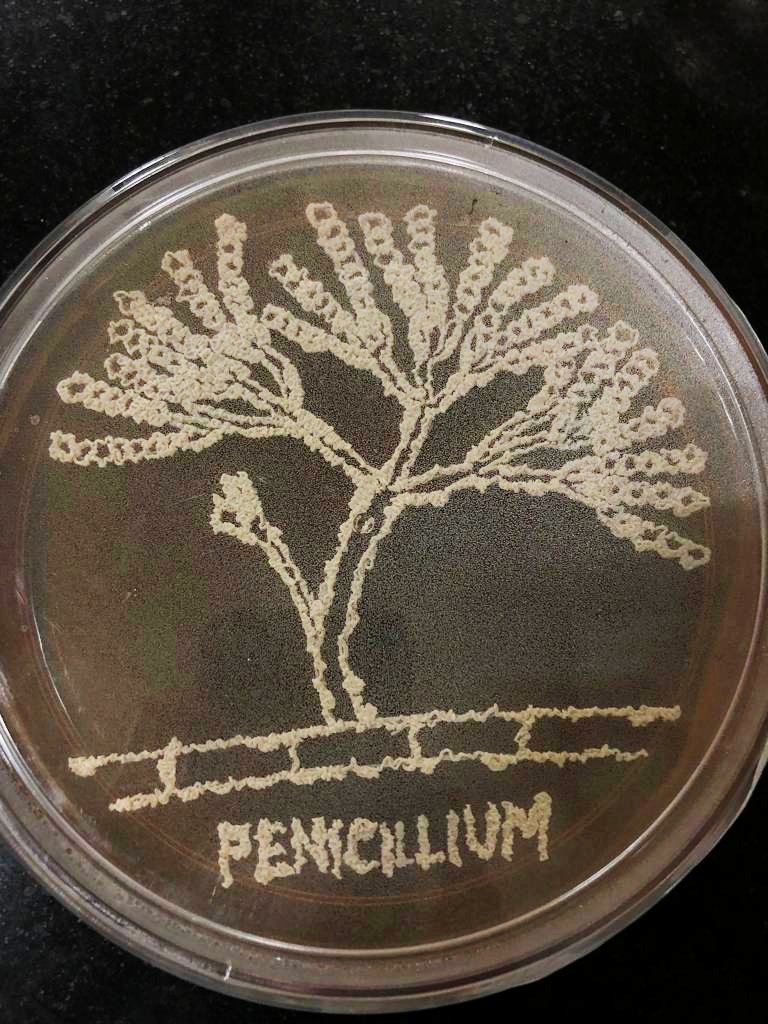
RamAvchar's tweet image. Happy National Science Day! NSD-2023 &quot;Global Science for Global Wellbeing&quot;@Openday @SciOutrAthab @NCMR_Pune @SharmaAavi @DBT_NCCS_Pune
 🔬 🧫🧬🧫

Saurabh Gaikwad
@saurabhg_16
Microbiology, Biohydrogen Production from Agricultural Waste, Anaerobes, Sulfate-reducing bacteria, Corrosion, and Phage. Researcher at @ari_pune
You might like
Happy to announce I’ve successfully defended my PhD thesis! My research focused on using #phages to inhibit #SulfateReducingBacteria associated with oil reservoir souring. Grateful for the mentorship & support @pkdhakephalkar & @dagarsumit #Bacteriophages #OilReservoirSouring


The #researchers from @ari_pune, an autonomous institute of @IndiaDST have uncovered the hidden potential of S. thermophilus often acclaimed for its role as a starter culture in various #dairy products, through a collaborative #genome analysis. @DrJitendraSingh @karandi65
New strain of lactic acid bacterium could be promising probiotic for the food and pharmaceutical industry Scientists have uncovered a new strain of lactic acid bacterium that could be a promising candidate for broader probiotic utilization beyond the dairy industry Read here:…



A Memorandum of Understanding was signed with @IISERPune to bring together the complementary expertise of the two institutions to advance understanding in basic sciences and technology. @pkdhakephalkar ,Director ARI Pune & Prof. Sunil S. Bhagwat, Director, @IISERPune signed MoU




Perfect for soy-based food industry, soybean variety MACSNRC 1667 is free of Kunitz Trypsin Inhibitor (KTi). KTi-free soybean enhances quality and digestibility of soy-based foods. Released by @ari_pune & @IisrIcar in 2022.@IndiaDST @DrJitendraSingh @karandi65 @pkdhakephalkar

@ari_pune शास्त्रज्ञ एस ए जायभाय आणि महाराष्ट्र राज्य कृषी विभागाच्या अधिकाऱ्यांनी दर्जेदार सोयाबीन बियाणे उत्पादन, बियाणे मानदंड आणि बियाणे प्लॉट रफिंग यावर मार्गदर्शन केले. साकोळ, लातूर येथील शेतकऱ्यांसाठी एक उत्तम उपक्रम! @IndiaDST @DrJitendraSingh @karandi65 @pkdhakephalkar


India’s first cultures of indigenous natural methane mitigating agents reported from rice fields and wetlands, mainly from Western India can help tackle upcoming climate challenges. While the world is experiencing global warming and climate change, there are some diligent…

On August 2, 2024, @ari_pune and @BITMesra_Ranchi signed an MoU to foster world-class research between the two institutions. MoU signed in the presence of Prof. (Dr.) Indranil Manna,Vice Chancellor,BIT Mesra & @pkdhakephalkar, Director, ARI @IndiaDST @DrJitendraSingh @karandi65




Happy to share that I have submitted my thesis! A step closer towards earning that degree. It wouldn’t have been possible without the efforts of so many people Immensely thankful to my guide @dagarsumit and mentor @pkdhakephalkar for supporting me through this journey. #PhDone

📢Excited to share our latest paper describing #Pseudodesulfovibrio thermohalotolerans sp. nov., a novel sulfate-reducing #bacterium isolated from a hydrocarbon reservoir in India. 🔗👉authors.elsevier.com/c/1hh7k3qfpmaf… Kudos to the team @ari_pune @pkdhakephalkar @dagarsumit @PoreSoham
The best way to look at Van Gogh’s Starry Night is to stare at the white dot for at least ten seconds, then look at the painting. Witness the rotation of a circular object with alternating black and white lines, spinning around a constant white point. Positioned below is an…
Interested in #bioethanol production from #lignocellulosic #biomass? Check out the positions for Project Scientist, Senior Project Associate, and Project Assistant in our labs @ari_pune Please follow the link below for more details👇 #biofuels #bioenergy aripune.org/wp-content/upl…
Don't waste your time on ChatGPT for academic writing. Introducing Paperpal – The perfect AI writing tool for academics. Here's how to take your writing to the next level:
Thanks to ChatGPT, hundreds of AI apps are being released every week now. But very few of them are meant for academic purposes. Here are 15 AI-powered apps to supercharge your academic writing and reading — with free tutorials:
Read this #Preprint from our lab describing methanogens of Indian hot spring environments. Ms Kasturi Deore carried out this work as a part of her PhD thesis #diversity #archaea #methane
New strain of lactic acid bacterium could be promising probiotic for the food and pharmaceutical industry Scientists have uncovered a new strain of lactic acid bacterium that could be a promising candidate for broader probiotic utilization beyond the dairy industry Read here:…



Happy National Science Day! NSD-2023 "Global Science for Global Wellbeing"@Openday @SciOutrAthab @NCMR_Pune @SharmaAavi @DBT_NCCS_Pune 🔬 🧫🧬🧫

Glad to be presenting my work at the International Conference #BSBB2022 @IITGuwahati on “Bio-agent to control SRB growth and H2S production to prevent souring of oil reservoir” @pkdhakephalkar @dagarsumit @PoreSoham @ari_pune @IndiaDST

Great day at #BSBB2022 so many great people, great content, great ideas! @IITGuwahati Talk on: Machine Learning Application in anaerobic co-digestion of food waste and sewage sludge by Prof. Samir Kumar Khanal

Received this whatsapp message from +917318688168 @MSEDCL please confirm the authenticity of

Live interview under the title "मी, आपण आणि विज्ञान" with three student researchers from ARI, namely @WadmareNeha, @sneehal22, and @ALagashetti. The discussion will be conducted by Dr. Mandar Datar on 29.04.2022 at 04:00 p.m. live on the page of ARI. #AmritMahotsav

United States Trends
- 1. #DWTS 18.5K posts
- 2. Carrie Ann 2,023 posts
- 3. Elaine 30.7K posts
- 4. Anthony Black N/A
- 5. Jalen Johnson 3,241 posts
- 6. Robert 93.8K posts
- 7. Alix 5,889 posts
- 8. Godzilla 29.2K posts
- 9. Wizards 7,658 posts
- 10. Brown 169K posts
- 11. Hazel 9,976 posts
- 12. Kingston Flemings N/A
- 13. #DancingWithTheStars N/A
- 14. #NXTGoldRush 3,748 posts
- 15. Joey Galloway 1,483 posts
- 16. House Party 7,566 posts
- 17. Bishop Boswell N/A
- 18. Seton Hall 2,288 posts
- 19. Araujo 195K posts
- 20. #iubb N/A
Something went wrong.
Something went wrong.






















































































































